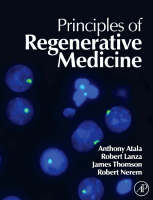
Principles of Regenerative Medicine -

Principles of Regenerative Medicine
Academic Press Inc (Verlag)
978-0-12-369410-2 (ISBN)
- Titel erscheint in neuer Auflage
- Artikel merken
Virtually any disease that results from malfunctioning, damaged, or failing tissues may be potentially cured through regenerative medicine therapies, by either regenerating the damaged tissues in vivo, or by growing the tissues and organs in vitro and implanting them into the patient. Principles of Regenerative Medicine discusses the latest advances in technology and medicine for replacing tissues and organs damaged by disease and of developing therapies for previously untreatable conditions, such as diabetes, heart disease, liver disease, and renal failure.
Anthony Atala, M.D., is the Director of the Wake Forest Institute for Regenerative Medicine, and the W.H. Boyce Professor and Chair of the Department of Urology at Wake Forest University. Dr. Atala is a practicing surgeon and a researcher in the area of regenerative medicine. His current work focuses on growing new human cells, tissues and organs. Dr. Atala works with several journals and serves in various roles, including Editor-in-Chief of Current Stem Cell Research and Therapy, and Therapeutic Advances in Urology; as Associate Editor of the Journal of Tissue Engineering and Regenerative Medicine, The Journal of Rejuvenation Research, Nanotechnology in Engineering and Medicine, Gene Therapy and Regulation, and Current Reviews in Urology; as Executive Board Member or Section Editor of the journal Tissue Engineering and International Journal of Artificial Organs, and as Editorial Board member of the International Journal of Stem Cells, Stem Cell Review Letters, Expert Opinion on Biological Therapy, Biomedical Materials, Recent Patents on Regenerative Medicine, the Journal of the American College of Surgeons, the Journal of Urology, BMC Urology, Urology, and Current Opinion in Urology. Dr. Atala is a recipient of the US Congress funded Christopher Columbus Foundation Award, bestowed on a living American who is currently working on a discovery that will significantly affect society, and the Gold Cystoscope Award for advances in his field. Dr. Atala was named by Scientific American as a Medical Treatments Leader of the Year for his contributions to the fields of cell, tissue and organ regeneration. In 2006, he was named by Fast Company magazine as one of 50 people who “will change how we work and live over the next 10 years. Dr. Atala’s work was listed as Discover Magazine`s Number 1 Top Science Story of the Year in the field of medicine, and as Time Magazine’s top 10 medical breakthroughs of the year in 2007. A Time Magazine poll ranked Dr. Atala as the 56th most influential person of the year in 2007. Esquire Magazine in 2008 named Dr. Atala one of the 75 most influential persons of the 21st century. Fast Company Magazine named Dr. Atala one of 100 Most Creative People in Business in 2009. Dr. Atala was featured in U.S. News & World Report as one of “14 Medical Pioneers Who Aren’t Holding Back. Dr. Atala has led or served several national professional and government committees, including the National Institutes of Health working group on Cells and Developmental Biology, and the National Institutes of Health Bioengineering Consortium. He is currently an NIH “Quantum Grant awardee. Dr. Atala heads a team of over 250 physicians and researchers. Ten applications of technologies developed in Dr. Atala's laboratory have been used clinically. He is the editor of nine books, including Minimally Invasive Urology, Methods of Tissue Engineering, Principles of Regenerative Medicine, and Foundations of Regenerative Medicine, and has published more than 300 journal articles and has applied for or received over 200 national and international patents. Robert Lanza is an American scientist and author whose research spans the range of natural science, from biology to theoretical physics. TIME magazine recognized him as one of the “100 Most Influential People in the World, and Prospect magazine named him one of the Top 50 “World Thinkers. He has hundreds of scientific publications and over 30 books, including definitive references in the fields of stem cells, tissue engineering, and regenerative medicine. He’s a former Fulbright Scholar and studied with polio-pioneer Jonas Salk and Nobel laureates Gerald Edelman (known for his work on the biological basis of consciousness) and Rodney Porter. He also worked closely (and co-authored papers in Science on self-awareness and symbolic communication) with noted Harvard psychologist BF Skinner. Dr. Lanza was part of the team that cloned the world’s first human embryo, the first endangered species, and published the first-ever reports of pluripotent stem cell use in humans.
Introduction to Regenerative Medicine
1
Current and Future Perspectives of Regenerative Medicine
Anthony Atala
Mark E. Furth
2
Fundamentals of Cell-Based Therapies
Ross Tubo
3
Stem Cell Research in Regenerative Medicine
Robert M. Nerem
AM Doyle
T Ahsan
Biologic and Molecular Basis of Regenerative Medicine
4
Molecular Organization of Cells
Carol A. Erickson
Jon D. Ahlstrom
5
Cell-ECM Interactions in Repair and Regeneration
Manuela Martins-Green
M. Petreaca
6
Developmental Mechanisms of Regeneration and Strategies of Regenerative Medicien
David L. Stocum
7
Molecular Basis of Pluripotency
Ali H. Brivanlou
Ariel J. Levine
8
How Cells Change Their Phenotype
Peter Andrews
Paul J. Gokhale
9
Somatic Cloning and Epigenetic Reprogramming in Mammals
Heiner Niemann
Christine Wrenzycki
Wilfried A. Kues
Andrea Lucas-Hahn
Joseph W. Warnwath
10
Transgenic Cloned Goats and Cows for the Production of Therapeutic Proteins
Harry Meade
William Gavin
LiHow Chen
David L. Melican
Carol A. Ziomek
Yann Echelard
Cells and Tissue Development
11
Genetic Approaches in Human Embryonic Stem Cells and Their Derivatives: Prospect for Regenerative Medicine
Mickie Bhatia
Junfeng Ji
Bonan Zhong
12
Embryonic Stem Cells: Derivation and Properties
James Thomson
Junying Yu
13
Stem Cells Derived from Amniotic Fluid and Placenta
Paolo De Coppi
Georg Van Dyke
M. Minhaj Siddiqui
Anthony Atala
14
Stem Cells Derived from Cord Blood
Julie Allickson
15
Multipotent Adult Progenitor Cells: Isolation and Induction
Catherine Verfaillie
16
Bone Marrow Stem Cells: Properties and Pluripotency
Ren Ke Li
Munira Xaymardan
Massimo Cimini
Richard D. Weisel
17
Hematopoietic Stem Cells: Properties , Markers and Therapeutics
M.A Goodell
S.M. Chambers
K.K. Lin
18
Neural Stem Cells: Multipotency Beyond Self-renewal and Phenotypic Differentiation
Evan Snyder
Yang D. Teng
Peter M. Black
F.N. Santos
Deniz Konya
Kook In Park
Richard L. Sidman
19
Mesenchymal Stem Cells
Daniel Gazit
Zumila Gazit
Hadi Aslan
Yossi Gafni
Nadav Kimelman
Gadi Pelled
20
Stem Cells and Maturational Lineage Biology: Implications for Clinical, Research and Commercial Programs
Lola Reid
Hsin-lei Yao
N. Cheng
21
Skeletal Muscle Stem Cells
Helen Blau
Jason H. Pomerantz
22
Islet Cell Therapy and Pancreatic Stem Cells
Camillo Ricordi
Juan Dominguez-Bendala
Antonello Pileggi
23
Regenerative Medicine for Diseases of the Retina
Thomas A. Reh
Deepak Lamba
24
Peripheral Blood Stem Cells
Shay Soker
Gunter Schuch
J. Koudy Williams
25
Prospects of Somatic cell Nuclear Transfer Derived Embryonic Stem Cells in Regenerative Medicine
Jose Cibelli
Z. Beyhan
26
Somatic Cells: Growth and Expansion Potential of T Lymphocytes
Rita B. Effros
27
Mechanical and Chemical Determinants of Tissue Development
David Kaplan
Jonathan A. Kluge
Gary G. Leisk
28
Morphogenesis, Bone morphogenetic Proteins and Regenerative Medicine
A. Hari Reddi
29
Physical Stress as a Factor in Tissue Growth and Remodeling
Robert Guldberg
Christopher S. Gemmiti
Yash Kolambkar
Blaise Porter
30
Engineering Cellular Microenvironments
Christopher S. Chen
Wendy F. Liu
Elliot E. Hui
Sangeeta N. Bhatia
31
Applications of Nanotechnology for Regenerative Medicine
Ben Harrison
32
Gene Chips in Regenerative Medicine
Jason Hipp
Anthony Atala
Biomaterials for Regenerative Medicine
33
Design Principles in Biomaterials and Scaffolds
Tae Gwan Park
Hyukjin Lee
34
Natural Polymers
Stephen Badylak
35
Synthetic Polymers
A.G. Mikos
M.C. Hacker
36
Hybrid, Composite, and Complex Biomaterials for Scaffolds
Hae Bang Lee
Gilson Khang
Hee Kim
Moon Suk Kim
37
Surface Modification of Biomaterials
Andres Garcia
38
Cell-Substrate Interactions in Regenerative Medicine
Kam W. Leong
Aparna Nori
Evelyn K.F. Yim
Sulin Chen
39
Histogenesis in Three Dimensional Scaffolds
Jennifer West
Nicole M. Bergman
40
Biocompatibility and Bioresponse to Biomaterials
James Anderson
41
Healing
William J. Lindblad
42
Precision Control of Proteins at Interfaces for Tissue Engineering and Regenerative Medicine
Buddy Ratner
Therapeutic Applications: Cell Therapy
43
Biomineralization and Bone Regeneration
Peter X. Ma
Jiang Hu
Xiaohua Liu
44
Blood Substitutes: Reverse Evolution from Oxygen Carrying to Non-Oxygen Carrying Plasma Expanders
Mark Van Dyke
Amy Tsai
Marcos Intaglietta
45
Articular Cartilage
Myron Spector
Francois Ng kee Kwong
46
Implantation of myogenic Cells in Skeletal Muscles
Jacques Tremblay
Daniel Skuk
47
Clinical Islet Transplantation
A.M. James Shapiro
Juliet A. Emamaulle
48
Cell-Based Repair for Regeneration and Neovascularization: What, Why, How and Where are We Going in the Next 5 - 10 Years?
Andrey G. Zenovich
49
Retinal pigment epithelium derived from embryonic stem cells
Irina Klimanskaya
50
Cell Therapies for Bone Regeneration
Scott P. Bruder
Rehan N. Khanzada
Chantal E. Holy
F. Jerry Volenec
51
Cell-Based Therapies for Musculoskeletal Repair
Rocky Tuan
Wan -Ju Li
David P. Patterson
George T.J. Huang
Kiran Gollapudi
52
Hepatocyte Transplantation
Steven C. Strom
Ewa C.S. Ellis
53
Bioartificial Livers
Lola Reid
Randall E. McClelland
54
Neuronal Transplantation for Stroke
Douglas Kondziolka
Lawrence Wechsler
55
Cell-Based Drug Delivery
Grace Lim
Therapeutic Applications: Tissue Therapy
56
Fetal Tissues
Chester Koh
Seyung Chung
57
Engineering of Large Diameter Vessels
George Christ
Saami K. Yazdani
58
Engineering of Small Diameter Vessels
Robert Tranquillo
Chrysanthi Williams
59
Vascular Assembly in Engineered and Natural Tissues
Larry V. McIntire
Eric M Brey
60
Cardiac Tissue
Michael V. Sefton
Milica Radisic
61
Regenerative Medicine in the Cornea
May Griffith
Heather Sheardown
62
Alimentary Tract
Mike Chen
63
Liver Cell-based Therapy in Regnerative Medicine - Bioreactors as Enabling Technology
Jorg Gerlach
Mariah Hout
Keneth Gage
Katrin Zeilinger
64
Kidney-Intracorporeal
James Yoo
65
Kidney
H. David Humes
William H. Fissell
66
Genitourinary System
Anthony Atala
67
Tissue Engineering of the Reproductive System
Roger De Filippo
68
Therapeutic Opportunities for Bone Grafting
Jeffrey O. Hollinger
John P. Schmitz
Thomas A. Einhorn
Gary E. Friedlaender
Chris R. Brown
Scott D. Bowden
Samuel Lynch
69
Cartilage Tissue Engineering
Jennifer Elisseeff
Paulesh Shah
Alexander Hillel
Ronald Silverman
70
Phalanges and Small Joints
Makoto Komura
James Yoo
71
Functional Tissue Engineering of Ligament and Tendon Injuries
Savio L.-Y. Woo
Alejandro J. Almarza
72
Tissue Therapy: Implications of Regenerative Medicine for Skeletal Muscle
Johnny Huard
Shen Wei
73
Central Nervous System
Molly Shoichet
Jordan H. Wosnick
M. Douglas Baumann
74
Peripheral Nerve Regeneration
Ravi Bellamkonda
Mahesh C. Dodla
75
Dental Tissue Engineering
Pamela Yelick
Yan Lin
76
Innovative Regenerative Medicine Approaches to Skin Cell-Based Therapy for Patiens with Burn Injuries
Jorg Gerlach
Steven E. Wolf
Christa Johnen
Bernd Hartman
77
Military Needs and Solutions in Regenerative Medicine
Alan Russell
Sara Wargo
Regulations and Ethics
78
Ethical Considerations
Louis M. Guenin
79
Religious Considerations
Laurie Zoloth
80
U.S. Stem Cell Research Policy: An Introduction
Josephine Johnston
81
Overview of FDA Regulatory Process
Celia Witten
Ashok Batra
Charles N. Durfor
Stephen H. Hilbert
Davis S. Kaplan
Donald Fink
Deborah Vavoie
Ellen Maher
Richard McFarland
82
Current Issues in U.S. Patent Law
Patrea Pabst
| Erscheint lt. Verlag | 4.12.2007 |
|---|---|
| Verlagsort | San Diego |
| Sprache | englisch |
| Maße | 216 x 279 mm |
| Gewicht | 3210 g |
| Themenwelt | Medizin / Pharmazie ► Medizinische Fachgebiete |
| Medizin / Pharmazie ► Physiotherapie / Ergotherapie ► Orthopädie | |
| Technik ► Medizintechnik | |
| ISBN-10 | 0-12-369410-8 / 0123694108 |
| ISBN-13 | 978-0-12-369410-2 / 9780123694102 |
| Zustand | Neuware |
| Informationen gemäß Produktsicherheitsverordnung (GPSR) | |
| Haben Sie eine Frage zum Produkt? |
aus dem Bereich



